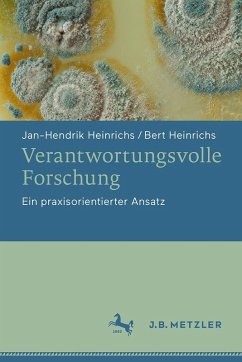
Verantwortungsvolle Forschung - Heinrichs, Jan-Hendrik;Heinrichs, Bert Verantwortungsvolle Forschung - Heinrichs, Jan-Hendrik;Heinrichs, Bert

Wissenschaft und Forschung müssen heute klarer reflektieren und deutlicher erklären, was sie tun und warum sie es tun. Dies betrifft nicht nur die Verwendung von öffentlichen Ressourcen, sondern auch Forschungsziele und methodische Ansätze. Insbesondere sind Wissenschaft und Forschung sehr viel stärker als früher zu zeigen aufgefordert, dass ihr Handeln ethisch verantwortungsvoll ist. Dafür müssen ethische Grundprinzipien und verfassungsmäßige Grundrechte regelmäßig gegeneinander abgewogen werden. Heutzutage sind also bereits bei der konzeptionellen Planung ethische und rechtliche Abwägungsfragen mitzubedenken und überzeugend zu beantworten. Neben fachwissenschaftlicher Expertise benötigen Forschende deshalb auch forschungsethische sowie rechtliche Kenntnisse. Ein verbreiteter Ansatz, um verantwortungsvolle Forschung zu gewährleisten, besteht darin, Mechanismen der akademischen Selbstregulierungen zu implementieren. Dies führt dazu, dass Forschende vermehrt in Gremien tätig werden, die die Projekte von anderen Forschenden ethisch begutachten. Der vorliegende Band bietet deshalb einen praxisorientierten Ansatz, der es Forschenden ermöglichen soll, sowohl ethische Probleme ihrer eigenen Arbeit zu identifizieren als auch Begutachtungstätigkeiten zu übernehmen. Er führt in etablierte Konzepte zur Handhabung ethischer Herausforderungen ein und vermittelt auch erforderliches rechtliches Hintergrundwissen für die Teilhabe in Ethik-Gremien und Kommissionen. Schließlich erläutern die Autoren, wie diese Konzepte genutzt werden können, um zu überzeugenden Lösungen für eine verantwortungsvolle Forschung zu gelangen.
Bitte wählen Sie Ihr Anliegen aus.
Rechnungen
Retourenschein anfordern
Bestellstatus
Storno